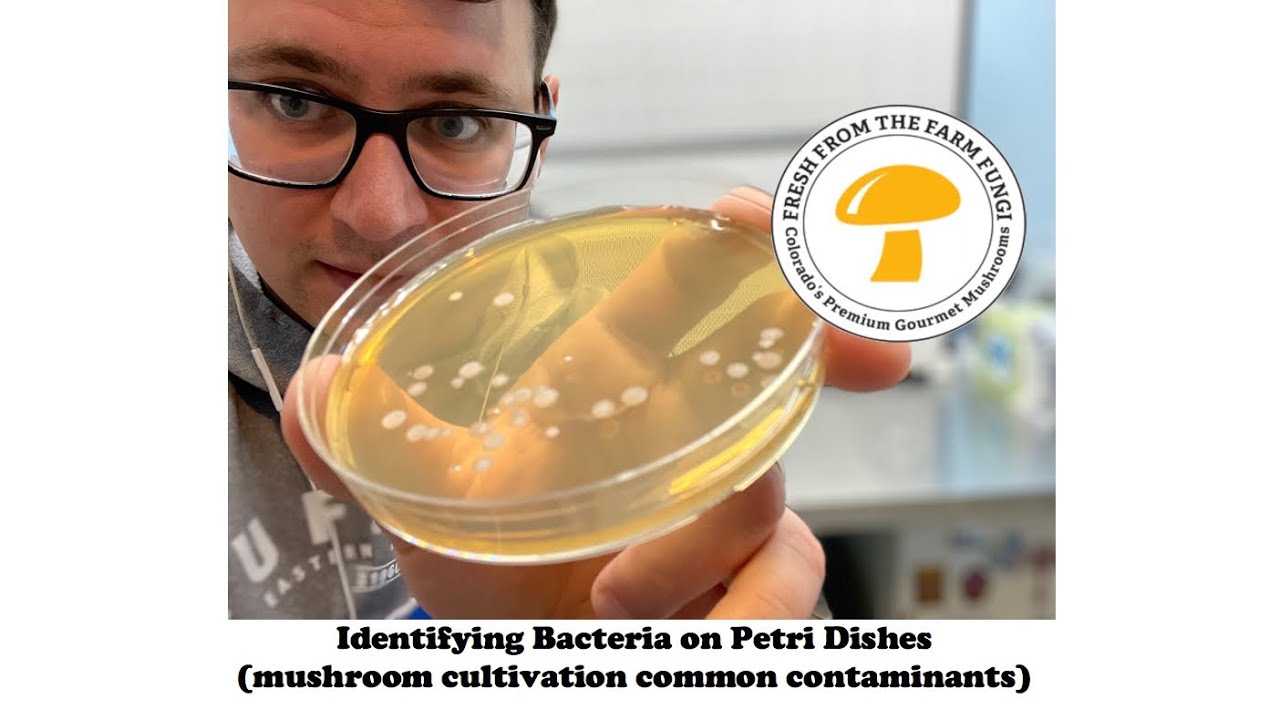
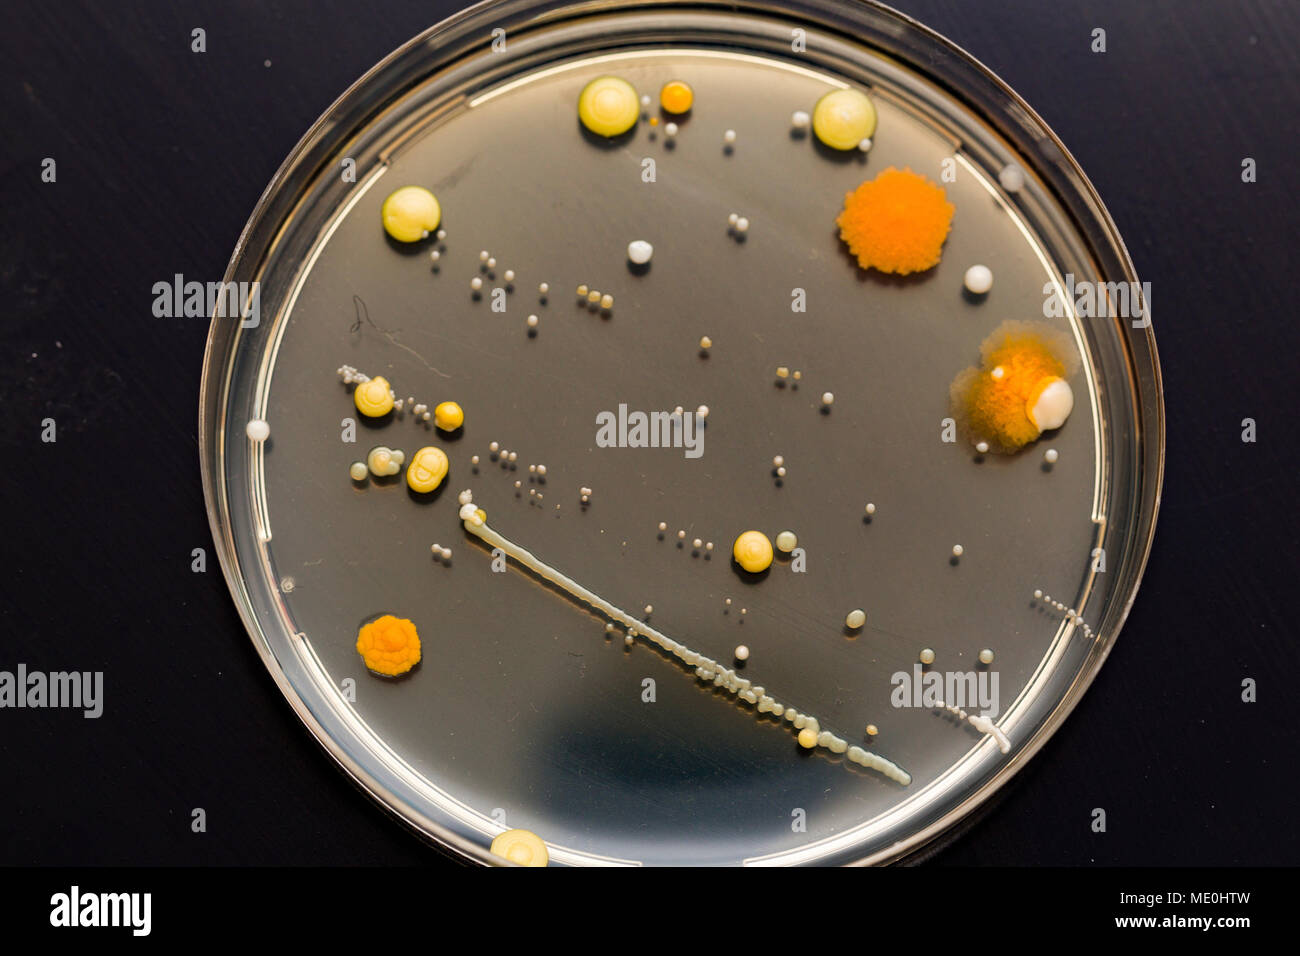

45 identifying bacteria in petri dishes
9020 QUALITY ASSURANCE/QUALITY CONTROL - Standard Methods for ... Record results. The following procedure is suitable for both Petri dishes and other glassware. a) Procedure—Wash and rinse six Petri dishes (Group A) according to usual laboratory practice. Wash six more Petri dishes (Group B) as above, and then rinse 12 times with successive portions of reagent water. Lifestyle | Daily Life | News | The Sydney Morning Herald WebThe latest Lifestyle | Daily Life news, tips, opinion and advice from The Sydney Morning Herald covering life and relationships, beauty, fashion, health & wellbeing
Rhizobium - Species, Nitrogen Fixation, Biofertilizer and Culture WebRhizobium Species, Nitrogen Fixation, Biofertilizer and Culture Overview. Rhizobium are a group of Gram-negative soil bacteria that are well known for their symbiotic relationship with various leguminous (soybeans, alfalfa etc).. There are different types of Rhizobium that are categorized on the basis of the rate of growth and the type of plant they are associated with.
Identifying bacteria in petri dishes
Join LiveJournal WebPassword requirements: 6 to 30 characters long; ASCII characters only (characters found on a standard US keyboard); must contain at least 4 different symbols; Identifying Bacteria Through Look, Growth, Stain and Strain Feb 07, 2020 · Armed with cotton swabs and Petri dishes full of nutient agar, students head out of the lab to see what lives on surfaces they encounter everyday. Many students choose to sample the places they consider dirtiest: toilet handles, doorknobs, or the floors in the school hallway (when I took my first microbiology lab course, I sampled the dorm ... DePaul University | DePaul University, Chicago WebOur Commitment to Anti-Discrimination. DePaul University does not discriminate on the basis of race, color, ethnicity, religion, sex, gender, gender identity, sexual orientation, national origin, age, marital status, pregnancy, parental status, family relationship status, physical or mental disability, military status, genetic information or other status protected …
Identifying bacteria in petri dishes. Could Call of Duty doom the Activision Blizzard deal? - Protocol Web14.10.2022 · Hello, and welcome to Protocol Entertainment, your guide to the business of the gaming and media industries. This Friday, we’re taking a look at Microsoft and Sony’s increasingly bitter feud over Call of Duty and whether U.K. regulators are leaning toward torpedoing the Activision Blizzard deal. How to Measure Bacterial Growth in Petri Dishes | Sciencing Web14.05.2018 · Bacteria are grown in Petri dishes upon a solid medium known as bacterial agar, where raised, circular colonies form. Unlike an individual bacterial cell, a colony is a group of bacteria large enough to be visible to the naked eye. Bacterial growth can be measured by simple observation of how many colonies are present; however, more … How to Distinguish Bacteria and Fungi: From Morphology to Sequencing WebThe size, shape, texture, color, margins of the colonies vary. Bacteria and fungi should be cultivated on agar in Petri dishes to examine colony morphology by supplying all the nutrients and conditions required. On agar media, bacteria emerge as tiny oily spots. All over the agar plate, fungi develop as powdery mats. The major distinction ... Mold Growing on Petri Dishes or Mold Culture Plates or WebPhotographs of mold culture test kit results: This article illustrates common results of mold test kits that use a culture medium, and along with several companion articles listed here, it explains the availability and usefulness of eye-level or low-power magnification photographs of mold growing on mold culture plates, settlement plates, and mold test kits to try to …
Agar for Mushroom Cultivation | Mycology Start WebThe mixture is dissolved in hot water, then pressure sterilized and finally poured into petri dishes. As the agar cools, it will solidify into a jello-like substance. Spore germination and mycelial growth are easily observed on the surface of the agar. Unwanted guests such as bacteria or other spores thrive on agar and will likely overtake the vulnerable mycelium. … DePaul University | DePaul University, Chicago WebOur Commitment to Anti-Discrimination. DePaul University does not discriminate on the basis of race, color, ethnicity, religion, sex, gender, gender identity, sexual orientation, national origin, age, marital status, pregnancy, parental status, family relationship status, physical or mental disability, military status, genetic information or other status protected … Identifying Bacteria Through Look, Growth, Stain and Strain Feb 07, 2020 · Armed with cotton swabs and Petri dishes full of nutient agar, students head out of the lab to see what lives on surfaces they encounter everyday. Many students choose to sample the places they consider dirtiest: toilet handles, doorknobs, or the floors in the school hallway (when I took my first microbiology lab course, I sampled the dorm ... Join LiveJournal WebPassword requirements: 6 to 30 characters long; ASCII characters only (characters found on a standard US keyboard); must contain at least 4 different symbols;

:max_bytes(150000):strip_icc()/growing_bacteria-5b56347ac9e77c0037c64487.jpg)











0 Response to "45 identifying bacteria in petri dishes"
Post a Comment